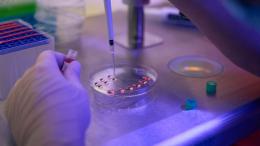

Ученые создали самую подробную карту человеческого тела для предсказания болезней

Британская благотворительная организация UK Biobank завершила крупнейший в мире проект по визуализации человеческого тела. За 15 лет команда ученых собрала данные от 100,000 добровольцев, включая МРТ-сканирование мозга, сердца, живота, костей и сосудов. Это стало новым прорывом в диагностике, профилактике и лечении заболеваний.
«Масштаб проекта беспрецедентен — более чем в 10 раз превышает все, что существовало ранее», — говорит профессор Рори Коллинз, руководитель UK Biobank.
Что такое UK Biobank?
Biobank — крупнейший в мире открытый биомедицинский ресурс. С 2006 года он собирает данные о здоровье, образе жизни и биологии от 500,000 жителей Великобритании. Цель проекта — ускорить научные открытия, помочь разрабатывать новые методы лечения и ранней диагностики заболеваний.
Теперь в арсенале исследователей появился новый мощный инструмент — самая подробная коллекция изображений человеческого тела.
В чем суть проекта?
С 2018 года 100 тысяч добровольцев прошли около пяти часов комплексного сканирования, включая:
-
магнитно-резонансную томографию (МРТ) мозга, сердца и органов брюшной полости;
-
ультразвуковое исследование сонных артерий;
-
сканирование костей и оценку уровня жира в организме.
Каждый участник также предоставил данные о своем образе жизни, а также образцы крови и ДНК. Общая инвестиция в проект составила 60 миллионов фунтов стерлингов.
«Теперь исследователи могут измерять размер, форму и структуру практически любого органа за секунды — раньше это занимало часы», — поясняет профессор Луиза Томас, эксперт по метаболической визуализации из Вестминстерского университета.
Собранные изображения дают возможность увидеть, как на здоровье влияет каждый аспект жизни — от генетики до уровня физической активности и питания. Например:
-
искусственный интеллект уже обучается распознавать первые признаки заболеваний сердца, Альцгеймера и Паркинсона задолго до появления симптомов;
-
ученые выясняют, что наши органы могут стареть быстрее, чем сам человек;
-
впервые стали изучать взаимосвязь между мозгом и сердцем на столь глубоком уровне.
«Сейчас мы разрабатываем ИИ-модель “здорового сердца” — она поможет выявлять болезни на ранних стадиях», — говорит один из исследователей.
На основе данных UK Biobank уже опубликовано более 1300 научных работ, и это только начало. Участники проекта — обычные люди. Как говорит Элисон, одна из добровольцев и член Консультативной группы:
«Я решила участвовать, чтобы создать более здоровое будущее для всех нас».
С расширением базы UK Biobank дает ученым все более мощные инструменты. Например, данные о 20,000 мозговых сканов уже используются вместе с показателями активности и генетикой для создания ИИ-прогноза риска нейродегенеративных болезней.
«Главное достоинство проекта — в его широте и глубине. С появлением новых сканов возможности станут еще шире, мы сможем предотвращать и лечить тысячи разных заболеваний», — говорит профессор Пол Мэтьюз, председатель рабочей группы UK Biobank по визуализации.